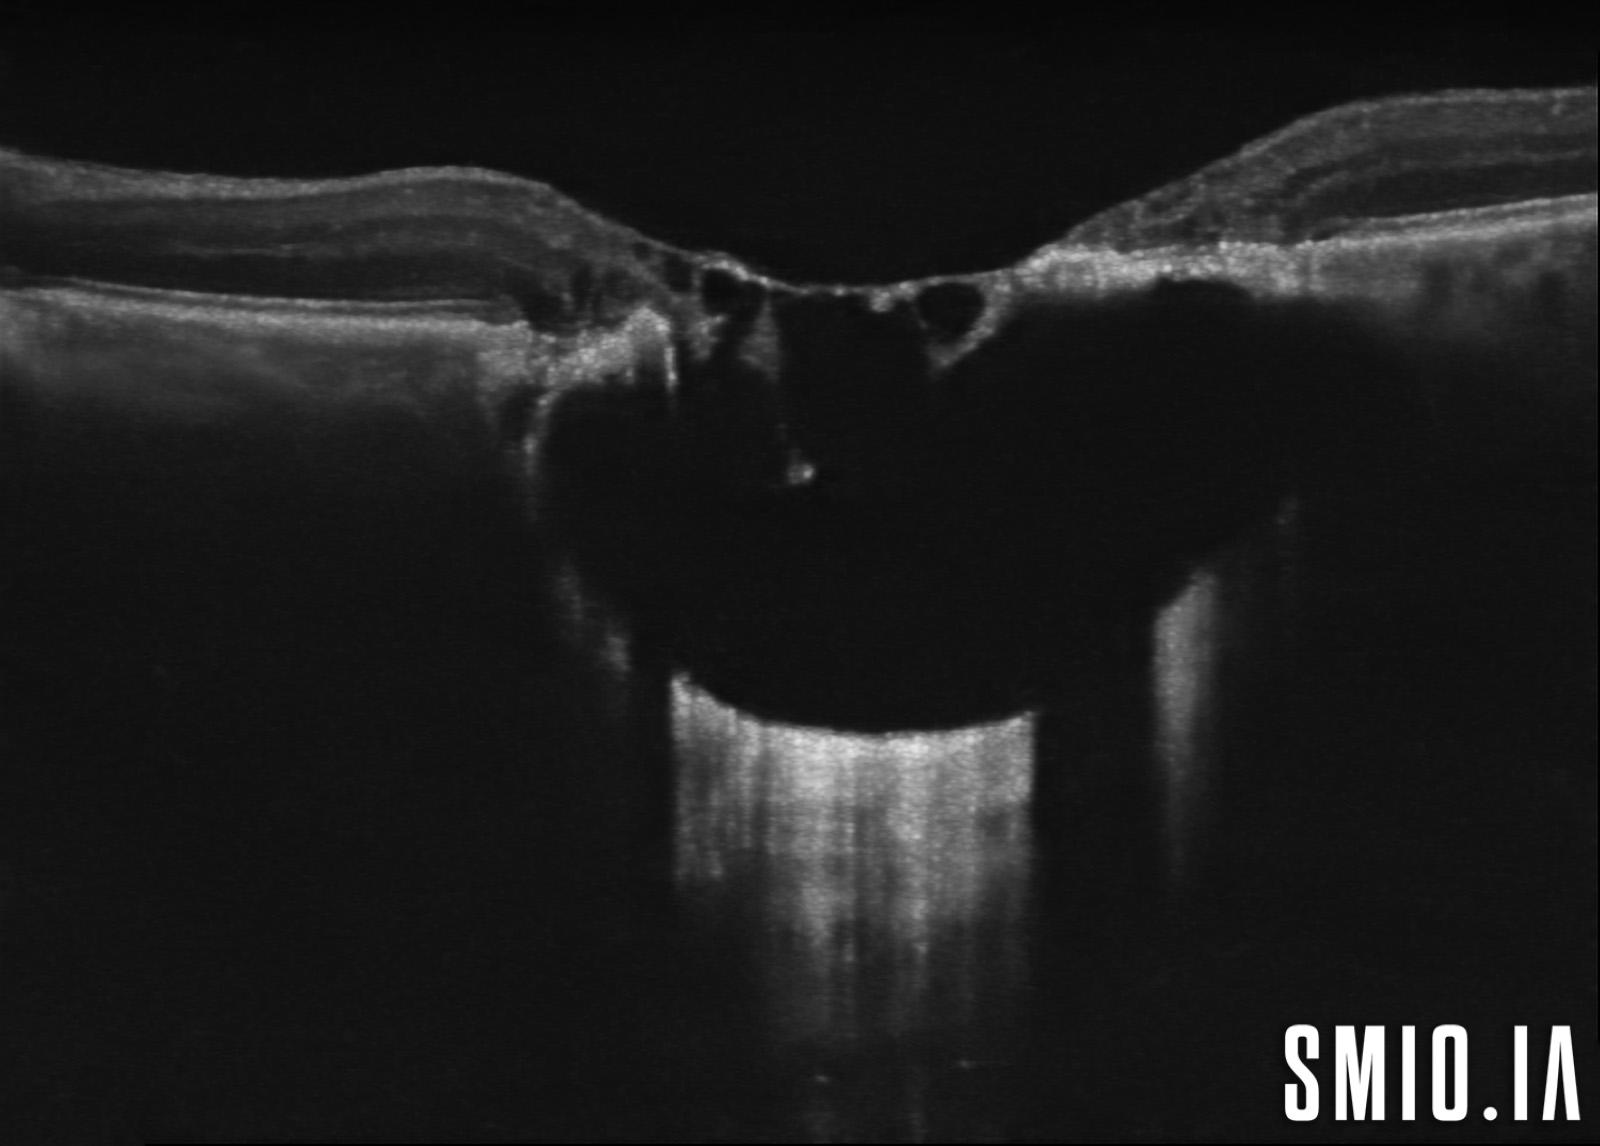
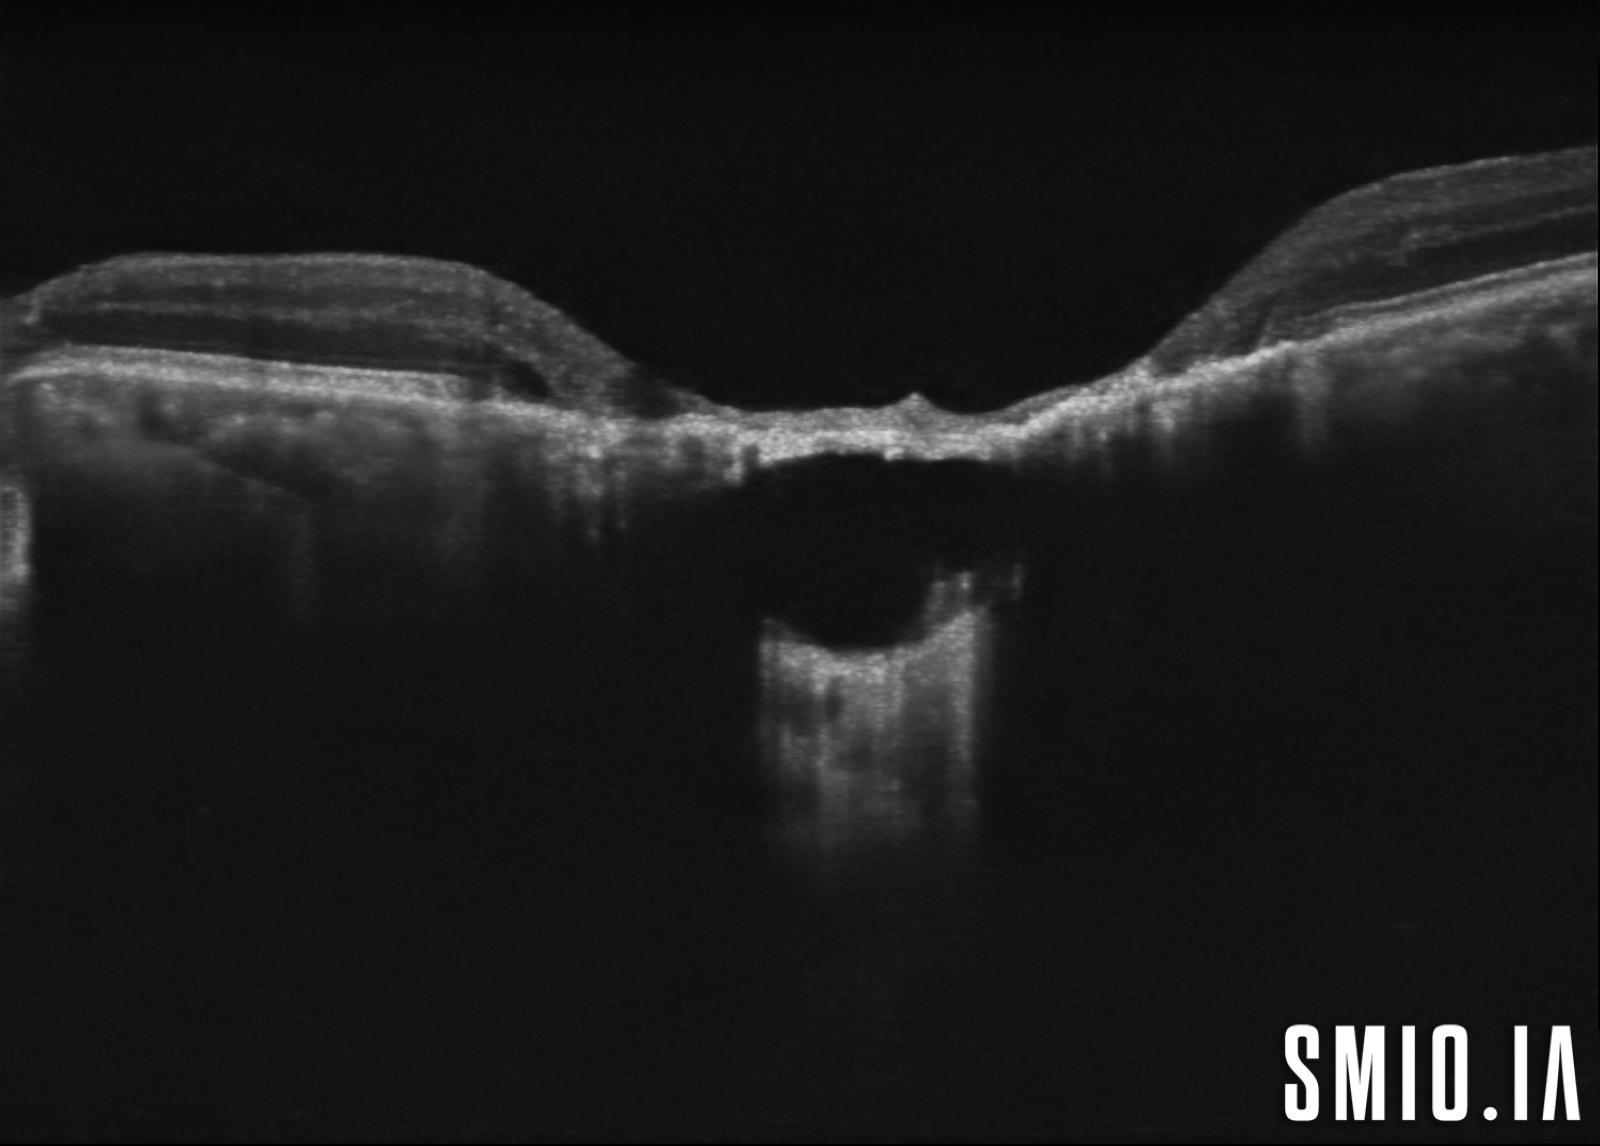

Cicatrice choriorétinienne de toxoplasmose oculaire congénitale

Uploadé le : 24 octobre 2024
0 J'aime
Vue(s): 313
Mots-clés
congénitale cicatrice toxoplasmose stéréo
Description: L'image stéréo d'une cicatrice choriorétinienne de toxoplasmose oculaire congénitale avec l'OCT à travers la lésion a démontré une grande lésion choriorétinienne excavée de colobome avec une cavitation intrachoroïdienne
Co-auteurs:
Appareil d'imagerie: EIDON AF Optol OCT Revo
Commentaires